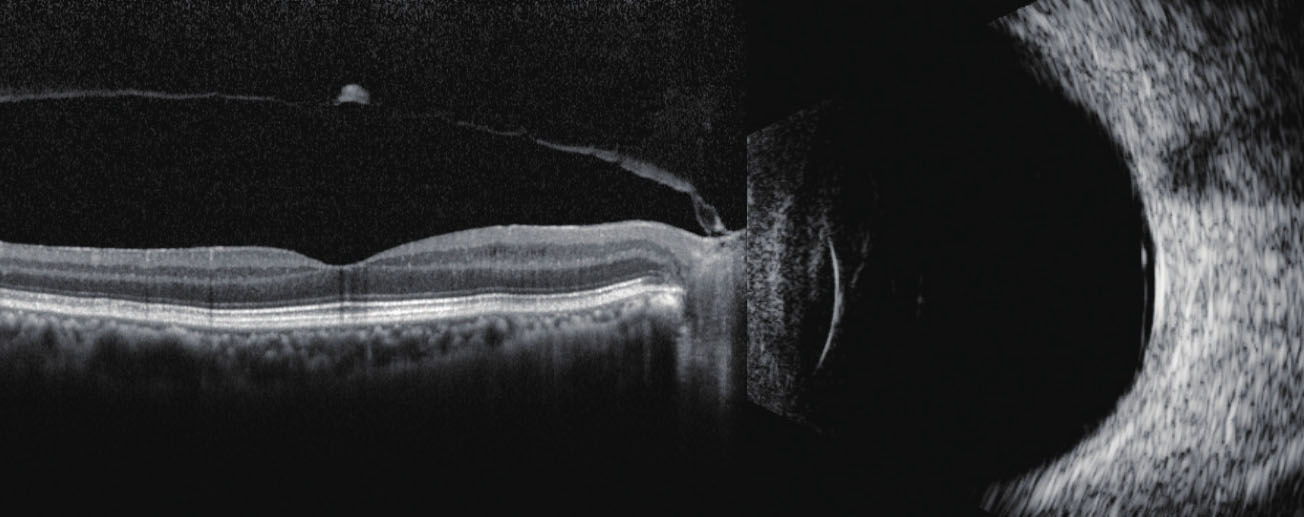

玻璃体后脱离(posterior vitreous detachment,PVD)指基底部以后的玻璃体与视网膜的分离。PVD可以发生在正常老年人中,也可以与玻璃体积血、炎症等有关。PVD分为完全性玻璃体后脱离和不完全性玻璃体后脱离两种。诊断玻璃体后脱离,对于预测许多玻璃体视网膜疾病的预后,决定玻璃体视网膜手术的适应证具有重要意义。糖尿病视网膜病变的患者出现玻璃体后脱离的时间晚于同年龄组的正常人,不完全性玻璃体后脱离附着在视网膜上的部位会成为视网膜新生血管的支架,视网膜新生血管一般不会出现在患有完全性玻璃体后脱离的眼睛中。
患者常感觉眼前有黑影飘动,在不完全性玻璃体后脱离时,由于玻璃体后皮质与视网膜未完全分离,在眼球转动产生剪切力时,动作电位经视网膜传导,患者会自觉出现闪光感,通常可在检眼镜下看到完全性玻璃体后脱离患者出现Weiss环。
完全性玻璃体后脱离常表现为连续纤细的膜样弱回声,不与后部球壁相连,动度及后运动实验阳性,在纤细的后脱离光带上可见到一斑片状中等回声,为Weiss环(图2—2)。当有血液及炎症碎屑在PVD的表面形成附着或分层时,超声图像常表现为略粗的膜样中等回声,动度及后运动实验呈阳性,活动度较大(图2—3)。不完全性玻璃体后脱离则表现为纤细的膜样回声两端与球壁相连,或一端与视盘相连,另一端与球壁相连,缺乏动度与后运动(图2—4)。部分不完全性脱离的玻璃体牵拉视网膜,经常导致视网膜出现小的裂孔,日久形成孔源性视网膜脱离,检查时需特别注意玻璃体与视网膜的关系(图2—5)。

图2—2 完全性玻璃体后脱离。眼底彩照可见Weiss环,B型超声可见玻璃体腔内的连续的膜样弱回声,在纤细的后脱离光带上可见斑片状中等回声,为Weiss环(白箭头)

图2—3 玻璃体积血伴玻璃体后脱离。后脱离的光带较粗大,动度及后运动活跃,且不与视盘相连
图2—4 不完全性玻璃体后脱离。OCT显示玻璃体后脱离的局部与视盘相连,B型超声显示黄斑区前方有细膜样弱回声,两端分别与视盘及球壁相连

图2—5 不完全性玻璃体后脱离。彩照见颞侧周边视网膜隆起,B型超声显示连续细膜样弱回声,视网膜浅脱离(箭头)
依据典型的超声表现,诊断PVD并不困难,值得注意的是,当有血液及炎症碎屑附着或分层时,需与视网膜脱离及脉络膜脱离进行鉴别。进行动度及后运动实验时,PVD活动度较大,典型的PVD会有波浪状的后运动,而视网膜脱离与脉络膜脱离一般仅有轻度的动度,可有轻度的后运动或无后运动。